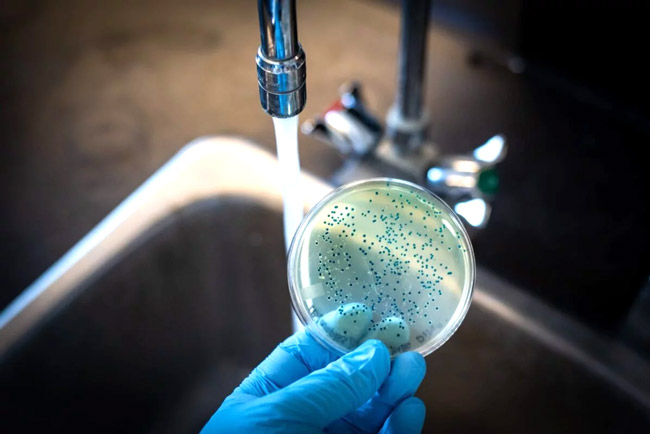

Bạn có bao giờ tự hỏi liệu nguồn nước mình đang dùng có thực sự sạch không? Việc kiểm tra chất lượng nước không hề phức tạp như bạn nghĩ. Hãy cùng Kanawa.vn tìm hiểu cách kiểm tra độ sạch của nước đơn giản và hiệu quả để bảo vệ sức khỏe cho bản thân và gia đình.
1. Làm sao để biết nước bị nhiễm khuẩn hay không?
Để biết nước có bị nhiễm khuẩn hay không, bạn có thể dựa vào một số dấu hiệu cảm quan và các phương pháp kiểm tra đơn giản. Nước nhiễm khuẩn thường có mùi lạ, đôi khi là mùi tanh hoặc mùi trứng thối do sự hiện diện của vi khuẩn và các hợp chất hữu cơ bị phân hủy. Màu sắc của nước cũng có thể thay đổi, trở nên đục, có màu vàng, nâu hoặc xanh rêu, đặc biệt khi có sự phát triển của tảo và vi sinh vật.

Khi đun sôi, nước nhiễm khuẩn có thể tạo ra cặn hoặc lớp váng trên bề mặt. Ngoài ra, việc sử dụng nước nhiễm khuẩn để tắm rửa hoặc giặt giũ có thể gây ngứa da, dị ứng hoặc các vấn đề về đường tiêu hóa nếu vô tình nuốt phải.
Tuy nhiên, những dấu hiệu này chỉ mang tính chất gợi ý ban đầu. Để có kết quả chính xác nhất, bạn cần sử dụng bộ test nhanh chuyên dụng hoặc gửi mẫu nước đến các phòng thí nghiệm để phân tích.
2. Các cách kiểm tra độ sạch của nước nhanh, hiệu quả
Để đảm bảo nguồn nước sinh hoạt an toàn, việc kiểm tra nhanh các chỉ số ô nhiễm phổ biến là vô cùng cần thiết. Dưới đây là những phương pháp hiệu quả để nhận biết sự hiện diện của asen, mangan, sắt, phèn, nitrit và clo trong nước.
2.1. Đối với asen
Asen là một chất độc hại không màu, không mùi, không vị nên rất khó nhận biết bằng cảm quan. Cách kiểm tra nhanh và hiệu quả nhất đối với asen là sử dụng bộ test kit thử asen chuyên dụng. Các bộ kit này thường hoạt động dựa trên phản ứng hóa học tạo ra sự thay đổi màu sắc trên que thử, giúp người so sánh với bảng màu chuẩn để xác định nồng độ asen có trong nước. Để đảm bảo độ chính xác, bạn cần tuân thủ đúng hướng dẫn sử dụng của nhà sản xuất.

2.2. Đối với mangan
Nước nhiễm mangan thường có màu vàng đục hoặc đen, có thể tạo thành các vết ố màu đen bám trên thành bồn rửa hoặc các vật dụng chứa nước. Khi nếm, nước có vị tanh nhẹ, đôi khi có vị chát hoặc lờ lợ.
Để kiểm tra nhanh, bạn có thể lấy một cốc nước và để yên trong vài giờ. Nếu thấy có lớp cặn màu đen hoặc nâu lắng xuống đáy cốc, khả năng cao nước đã bị nhiễm mangan. Ngoài ra, bạn cũng có thể sử dụng các thiết bị đo đa chỉ tiêu có chức năng kiểm tra mangan để có kết quả chính xác hơn.

2.3. Đối với sắt, phèn
Nước nhiễm sắt và phèn thường có màu vàng, nâu đỏ hoặc có váng màu vàng cam nổi trên bề mặt khi tiếp xúc với không khí. Nước có vị tanh nồng, đôi khi hơi chua và làm quần áo bị ố vàng khi giặt.
Cách kiểm tra đơn giản là lấy một lượng nước vào cốc thủy tinh trong suốt và để yên khoảng 15-30 phút. Nếu thấy nước chuyển sang màu vàng hoặc có kết tủa màu nâu đỏ bám vào thành cốc, đó là dấu hiệu của sắt và phèn. Đối với phèn, nước cũng có thể gây cảm giác ngứa ngáy, khô da sau khi tắm.

2.4. Đối với nitrit
Nitrit là một chất gây hại cho sức khỏe, thường không có màu, mùi hay vị rõ ràng. Cách kiểm tra nhanh nitrit hiệu quả là sử dụng que thử nitrit hoặc bộ test kit chuyên dụng. Những bộ test này sẽ phản ứng với nitrit trong nước và tạo ra sự thay đổi màu sắc trên que thử hoặc dung dịch, giúp bạn so sánh với bảng màu để ước lượng nồng độ. Việc kiểm tra nitrit đặc biệt quan trọng nếu nguồn nước của bạn gần các khu vực nông nghiệp hoặc khu vực có hệ thống xử lý nước thải không đảm bảo.

2.5. Đối với clo
Clo thường được sử dụng để khử trùng nước nhưng nồng độ clo dư quá cao có thể gây khó chịu và ảnh hưởng đến sức khỏe. Nước có mùi clo nồng nặc là dấu hiệu dễ nhận biết nhất.
Bạn cũng có thể kiểm tra bằng cách dùng bộ test clo chuyên dụng (thường là dung dịch OTO hoặc DPD). Khi nhỏ vài giọt dung dịch này vào mẫu nước, nếu nước chuyển sang màu vàng (với OTO) hoặc hồng/đỏ (với DPD) tùy thuộc vào nồng độ clo, điều đó cho thấy nước có clo dư. Mức độ đậm nhạt của màu sắc sẽ tương ứng với nồng độ clo trong nước.

3. Một số dụng cụ, thiết bị cần trang bị khi kiểm tra độ sạch của nước
Để đánh giá chính xác chất lượng nguồn nước sinh hoạt, việc trang bị những dụng cụ và thiết bị chuyên dụng là cần thiết. Dưới đây là hai công cụ phổ biến và hữu ích giúp bạn kiểm tra độ sạch của nước một cách nhanh chóng và hiệu quả.
3.1. Bút thử nước TDS
Bút thử nước TDS (Total Dissolved Solids) là một thiết bị nhỏ gọn, dễ sử dụng, dùng để đo tổng lượng chất rắn hòa tan trong nước. Các chất rắn này có thể bao gồm khoáng chất, muối, kim loại hoặc các tạp chất hữu cơ. Mặc dù bút TDS không thể xác định loại tạp chất cụ thể hay phát hiện vi khuẩn nhưng nó là công cụ hữu ích để đánh giá mức độ “sạch” tổng thể của nước.

Chỉ số TDS cao thường cho thấy nước chứa nhiều chất hòa tan, có thể ảnh hưởng đến mùi vị và đôi khi là sức khỏe nếu các chất đó là độc hại. Để sử dụng, bạn chỉ cần nhúng đầu bút vào mẫu nước, thiết bị sẽ hiển thị chỉ số TDS trên màn hình điện tử, giúp bạn nhanh chóng so sánh với các tiêu chuẩn an toàn.
3.2. Máy đo chất lượng nước
Máy đo chất lượng nước là thiết bị đa năng hơn so với bút TDS, cho phép kiểm tra nhiều chỉ số quan trọng khác nhau của nước. Các loại máy cao cấp hơn có thể tích hợp cảm biến để phát hiện clo dư, nitrit hay amoniac.

Với khả năng cung cấp thông tin chi tiết và toàn diện hơn, máy đo chất lượng nước giúp bạn có cái nhìn tổng quan và chính xác về tình trạng ô nhiễm trong nguồn nước. Thiết bị này thường được sử dụng bởi các hộ gia đình có nhu cầu kiểm tra sâu rộng, các cơ sở kinh doanh nước uống.
>>> Mách bạn kinh nghiệm mua máy làm đá viên cho đá sạch tinh khiết, giá tốt
4. Một số cách chữa cháy khi nước bị nhiễm khuẩn
Khi phát hiện nước có dấu hiệu bị nhiễm khuẩn, việc áp dụng các biện pháp xử lý kịp thời là vô cùng quan trọng để bảo vệ sức khỏe. Dưới đây là hai cách phổ biến và hiệu quả để loại bỏ vi khuẩn khỏi nguồn nước.
4.1. Đun sôi nước
Đun sôi nước là phương pháp truyền thống và hiệu quả nhất để tiêu diệt hầu hết các loại vi khuẩn, vi rút và ký sinh trùng gây bệnh có trong nước. Khi nước đạt nhiệt độ sôi (100°C) và được duy trì sôi trong ít nhất 1 phút, các mầm bệnh sẽ bị tiêu diệt, giúp nước trở nên an toàn hơn để uống và sinh hoạt.

Đây là một giải pháp khẩn cấp, dễ thực hiện khi bạn nghi ngờ nguồn nước bị ô nhiễm hoặc khi không có sẵn các thiết bị lọc hiện đại. Mặc dù đun sôi có thể loại bỏ vi khuẩn, nó không loại bỏ được các hóa chất độc hại hay kim loại nặng hòa tan trong nước.
4.2. Sử dụng hệ thống lọc nước
Để có giải pháp lâu dài và toàn diện hơn, sử dụng hệ thống lọc nước là lựa chọn tối ưu. Các hệ thống lọc nước hiện đại, có khả năng loại bỏ không chỉ vi khuẩn, vi rút mà còn cả các kim loại nặng, hóa chất, clo dư và các tạp chất khác, mang lại nguồn nước tinh khiết.

Đối với những nhu cầu đặc biệt như sản xuất đá viên tinh khiết, việc trang bị máy làm đá viên có tích hợp bộ lọc nước tinh khiết là giải pháp lý tưởng. Hệ thống lọc này đảm bảo nước được làm sạch hoàn toàn trước khi chuyển hóa thành đá, giúp đá viên không chỉ trong suốt mà còn an toàn tuyệt đối cho người sử dụng.
Hy vọng rằng với những hướng dẫn cách kiểm tra độ sạch của nước đơn giản và chính xác này, bạn đã có thể tự tin đánh giá chất lượng nguồn nước mình đang sử dụng. Việc chủ động kiểm tra sẽ giúp bạn đưa ra những quyết định đúng đắn để bảo vệ sức khỏe cho bản thân và gia đình.